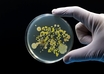

Methotrexate use is linked to an increased risk of skin cancer: Study
ANI | Feb 08, 2023
Study finds new cell death mechanism helps to treat cancer
ANI | Feb 08, 2023
Curtailing pollution must to reduce superbugs: UN report
IANS | Feb 08, 2023
Gene-edited babies living happily with parents, says scientist who created them
IANS | Feb 08, 2023
Vitamin D supplements linked with lower diabetes risk: Study
PTI | Feb 08, 2023
Study: Having quality conversation with a friend can boost daily well-being
ANI | Feb 07, 2023
Mayo Clinic opens patient information office in India
IANS | Feb 07, 2023
Hearing personal experiences can increase COVID vaccination rates: Study
IANS | Feb 07, 2023
Consumption of ultra-processed food linked to cancer
ANI | Feb 07, 2023
Study reveals risk factors of chronic kidney disease in children
ANI | Feb 07, 2023
Most read this week